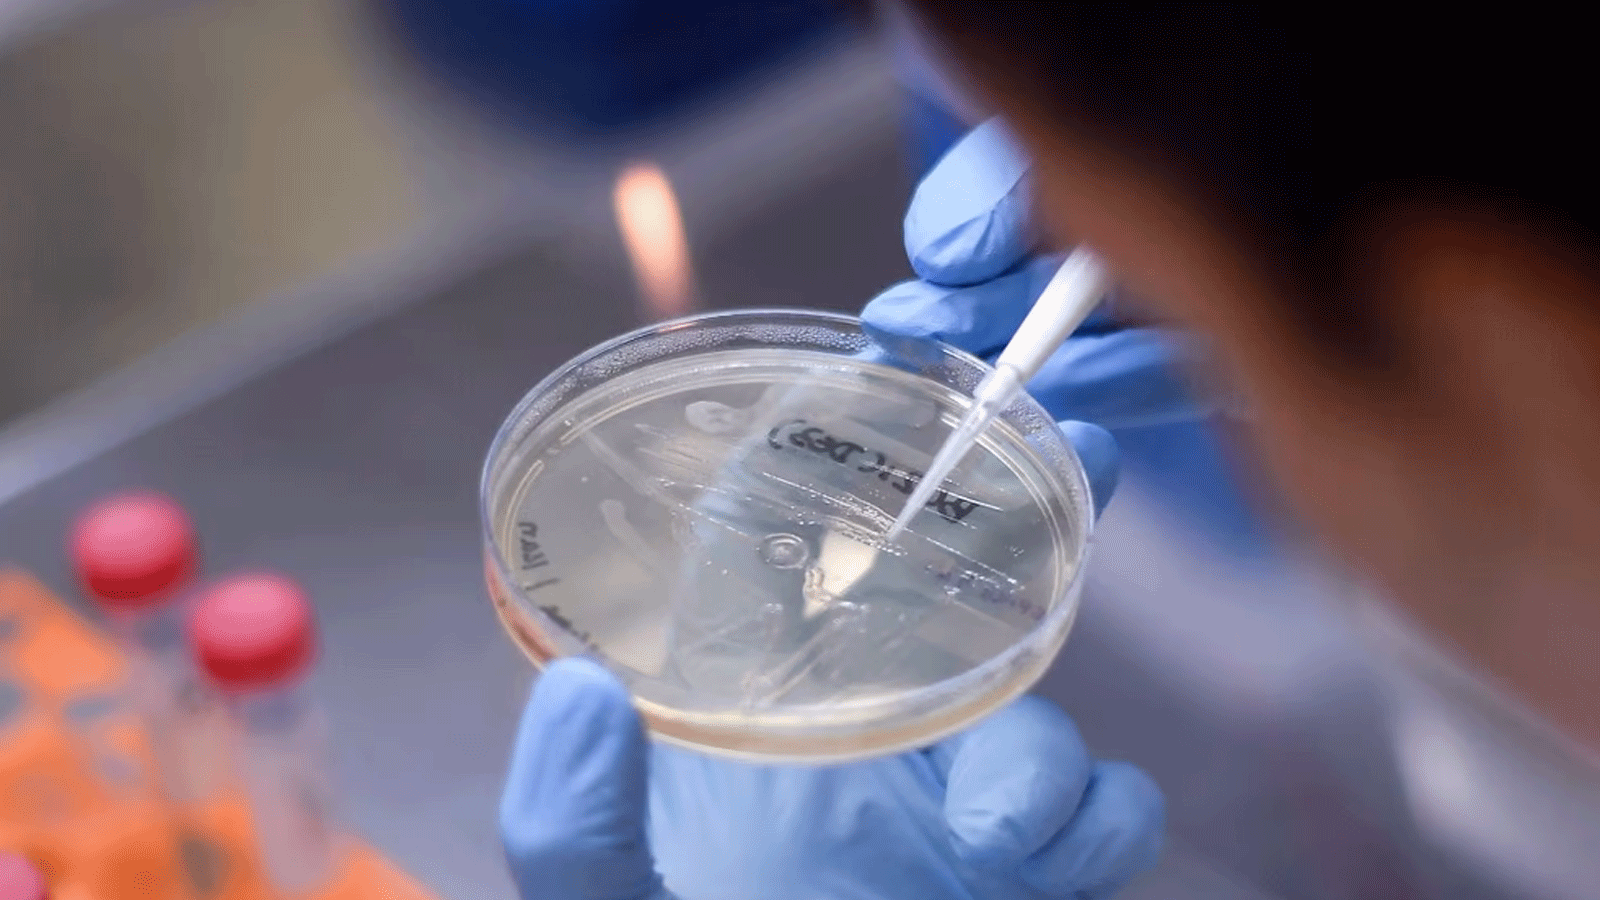
قمة لوضع جهوزية عالية للتمكن من إنتاج لقاحات بسرعة

إيلاف من لندن: قالت العالمة التي وقفت وراء إنجاز لقاح أكسفورد، إنه يجب على العالم إطلاق حقنة الفيروس الوبائي القادم في غضون 100 يوم فقط.
وقالت البروفيسور السيدة سارة جيلبرت إن الأمر استغرق حوالي 300 يوم من التعرف على كورونا COVID-19 إلى الموافقة على اللقاحات الأولى، ولكن لمنع حدوث جائحة في المستقبل، يجب أن تكون الاستجابة أسرع بكثير.
وحثت العالمة جيلبرت، العالم على إطلاق جرعة من الفيروس الوبائي القادم - ما يسمى بالمرض X - في غضون 100 يوم فقط.

البروفيسور سارة جيلبرت
استجابة أسرع
وفي مقابلة مع قناة (سكاي نيوز)، قالت البروفيسور سارة جيلبرت إن الأمر استغرق حوالي 300 يوم من تحديد COVID-19 في الصين إلى موافقة السلطات الطبية على اللقاحات الأولى، ولكن لمنع التأثير الكارثي لوباء في المستقبل، يجب أن تكون الاستجابة أسرع بكثير.
وقالت: "نحن لا نتحدث عن فعل الشيء نفسه مرة أخرى وفعله بشكل أسرع، وما نتحدث عنه الآن هو الاستعداد بشكل أفضل، لذلك لا يتعين علينا البدء من نفس المكان في المرة القادمة."
قمة
وستنضم البروفيسور جيلبرت إلى المدير العام لمنظمة الصحة العالمية، والمستشار الطبي لرئيس الولايات المتحدة البروفيسور أنتوني فوسي، ورؤساء شركات الأدوية وممثلي الحكومة في قمة التأهب للأوبئة العالمية في لندن.
وتم وضع هدف "المائة يوم" في الأصل من قبل حكومة المملكة المتحدة خلال رئاستها لمجموعة السبع في يونيو 2021، وبدعم من قادة مجموعة السبع ومجموعة العشرين.
ومثل هذه الاستجابة السريعة لـ COVID كانت ستنقذ ملايين الأرواح وتريليونات الدولارات حول العالم.
وتعهدت حكومة المملكة المتحدة بتقديم 160 مليون جنيه إسترليني لبدء ما تسميه "مهمة المائة يوم"، ويشترك في استضافة القمة تحالف ابتكارات التأهب للأوبئة (CEPI) وحكومة المملكة المتحدة.
وقال الدكتور ريتشارد هاتشيت ، رئيس CEPI: "تعد قمة التأهب للأوبئة العالمية علامة بارزة في رحلتنا نحو جعل الأوبئة شيئًا من الماضي، لدينا فرصة سانحة للتعلم من التجارب الرهيبة التي شهدناها خلال العامين الماضيين وبناء عالم مستعد لمواجهة التهديد الوبائي القادم."
مكتبة لقاحات
وإلى ذلك، قالت البروفيسورة جيلبرت إن العلماء بحاجة إلى بناء مكتبة لقاحات ضد عائلات الفيروسات التي تشكل أكبر التهديدات الوبائية. قد يعني ذلك ما لا يقل عن 10 لقاحات فعالة على نطاق واسع لتبدأ بها.
وقالت "نريد أن نجعل مخزون البذور (العينة المرجعية للفيروس) لعدد من اللقاحات المختلفة". وأضافت: "ثم نبدأ في إجراء الاختبارات السريرية حتى نتمكن من النظر في الاستجابة المناعية لكل نوع من أنواع الفيروسات المختلفة لمعرفة ما إذا كان من المحتمل أن يكون وقائيًا.
وقالت: "نريد أن نذهب إلى أبعد ما نستطيع ومن ثم نمتلك مخزونًا صغيرًا من اللقاح جاهزًا للاستخدام والقدرة على تكثيف التصنيع بسرعة كبيرة في حالة تفشي المرض".
مصدر قلق
ولا تزال عائلة الفيروس التاجي مصدر قلق كبير بسبب قدرتها على الانتشار السريع بين الناس. والبعض الآخر، مثل فيروس "نيباه" لديه معدل وفيات مرتفع ، لكنه أقل قابلية للانتقال حتى الآن.
وهناك تحديات كبيرة في إنتاج لقاح في 100 يوم فقط، بما في ذلك توافر الاختبارات التشخيصية وطريقة أسرع لقياس فعالية اللقاح مقارنة بالتجارب السريرية التقليدية.
وستكون هناك حاجة إلى المزيد من مواقع التصنيع، لا سيما في إفريقيا، لتسريع عملية طرحها. وقالت البروفيسور جيلبرت: "لقد تعلمنا الكثير من COVID وعلينا الآن التأكد من أننا نستفيد من ذلك - انظر ما الذي نجح بشكل جيد وما الذي لم ينجح. يمكننا أن نذهب أسرع بكثير، وجعل الأوبئة شيئًا من الماضي".